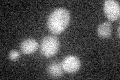
YKR039W
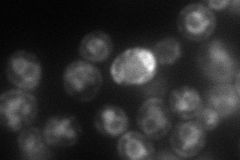
YKR039W
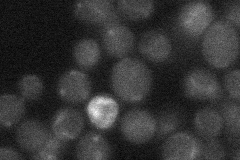
YKR039W
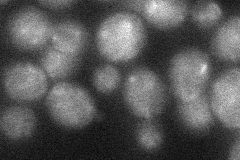
YKR039W
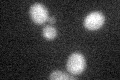
YKR039W

View description
General amino acid permease; localization to the plasma membrane is regulated by nitrogen source
Localization:
Intensity:
Fold change:
Significance:
-
C’ GFP library in SD
below threshold15.58 -
N' NOP1pr-GFP in SD

ER77.5348 -
N' TEF2pr-mCherry in SD
ER,vacuole68.3271 -
N' NATIVEpr-GFP in SD
below threshold19.8097 -
N' TEF2pr-VC and Cyto-VN in SD
punctate32.4636 -
C’ GFP library in SD+DTT
cytosol15.360.98No -
C’ GFP library in SD+H2O2

cytosol16.251.04No -
C’ GFP library in Starvation Media

cytosol16.791.07No -
C’ GFP library on the background of Pup2-DaMP

below threshold -
C’ GFP library on the background of CCT mutant

below threshold14.57870.935451No
